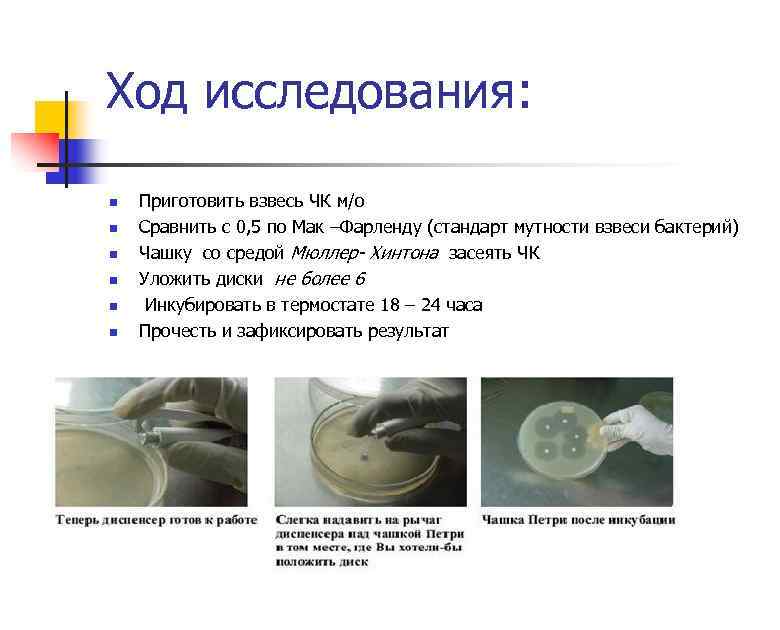
Ход исследования: n n n Приготовить взвесь ЧК м/о Сравнить с 0, 5 по

Антибиотики. Методы определения чувствительности к антибиотикам..ppt
- Количество слайдов: 63

Тема: Антибиотики. Методы определения чувствительности к антибиотикам. Сокращения: БГСА – β–гемолитический стрептококк группы А (S. pyogenes) MRSA – метициллинорезистентный S. aureus PRSA – пенициллинорезистентный S. aureus БЛРС – β–лактамазы расширенного спектра ГОБ – гематоофтальмический барьер ГЭБ – гематоэнцефалический барьер Т 1/2 – период полувыведения

КЛАССИФИКАЦИЯ АНТИБИОТИКОВ n По происхождению: Способ получения Продуцент Примеры • • • Собственно бактерии • Грамицидин полимиксин • Актиномицеты • • Грибы Стрептомицин, эритромицин, тетрациклины и др. • Бензилпенициллин, цефалоспорины, фузидиевая кислота Природные (биосинтетические) С, • • Полусинтетические (комбинация биосинтеза и химического синтеза • Продукты модификации молекул природных антибиотиков • Оксациллин, ампициллин, гентамицин, рифампицин и др. • Синтетические • Аналоги природных антибиотиков, синтезированных химическим путем • Левомицетин, амикацин

КЛАССИФИКАЦИЯ АНТИБИОТИКОВ n n n n По спектру антимикробной активности: Антибактериальные Противогрибковые Антипротозойные По типу действия: бактерицидные - необратимо связываются с клеточными мишенями, вызывая гибель чувствительных к ним микроорганизмов. (пенициллины, цефалоспорины, аминогликозиды, рифампицин, полимиксины и др. ); бактериостатические - ингибируют рост и размножение микробных клеток, но при удалении антибиотика жизнедеятельность возбудителей восстанавливается (макролиды, тетрациклины, линкомицин, хлорамфеникол и др. ).

КЛАССИФИКАЦИЯ АНТИБИОТИКОВ По спектру действия: n 1) с преимущественным действием на грамположительные микроорганизмы (линкозамиды, биосинтетические пенициллины, цефалоспорины 1 -го поколения, макролиды, ванкомицин, линкомицин); n 2) с преимущественным действием на грамотрицательные микроорганизмы (монобактамы, циклические полипептиды, цефалоспорины 3 -го поколения); n 3) широкого спектра действия (аминогликозиды, левомицетин, тетрациклины, полусинтетические пенициллины широкого спектра действия (ампициллин, азлоциллин и др. ) и цефалоспорины 2 го поколения). n 4) Противотуберкулезные антибиотики (стрептомицин, рифампицин, флоримицин). n 5) Противогрибковые антибиотики (нистатин, леворин, гризеофульвин, амфотерицин В, кетоконазол, анкотил, дифлюкан и др. ).

КЛАССИФИКАЦИЯ АНТИБИОТИКОВ • • выделяют антибиотики первой очереди (пенициллины, макролиды, аминогликозиды), второй очереди (цефалоспорины, полусинтетические аминогликозиды, аугментин и пр. ) и резервные (фторхинолоны, карбопенемы). Выделяют антибиотики короткого и пролонгированного действия. Так, для поддержания бактерицидной концентрации в плазме пенициллин следует вводить каждые 4 часа, а роцефин (цефалоспорин 3 поколения) - 1 раз в сутки. По токсичности разделяют ото-, нефро-, гепато-, нейротоксичные и т. д. Выделяют антибиотики со строго регламентированной дозой применения (линкозамины, аминогликозиды и пр. ) и препараты, дозу которых можно увеличивать в зависимости от выраженности инфекционного процесса (пенициллины, цефалоспорины).

По химическому строению: n 1) b-лактамные антибиотики. К ним относятся: а) пенициллины, среди которых выделяют природные (аминипенициллин) и полусинтетические (оксациллин); б) цефалоспорины (цепорин, цефазолин, цефотаксим); в) монобактамы (примбактам); г) карбапенемы (имипинем, меропинем, эртапенем); n 2) аминогликозиды (канамицин, неомицин); n 3) тетрациклины (тетрациклин, метациклин); n 4) макролиды (эритромицин, азитромицин, мидекамицин); n 5) линкозамины (линкомицин, клиндамицин); n 6) полиены (амфотерицин, нистатин); n 7) гликопептиды (ванкомицин, тейкоплакин): n 8) оксазолидиноны (линезолид)

КЛАССИФИКАЦИЯ АНТИБИОТИКОВ по химическому строению n Характеристика молекулярной структуры n Основные группы антибиотиков n n n Содержащие бета-лактамное кольцо n Пенициллин ы n n —"— n n n Содержащие аминосахара Содержащие n Цефалоспор ины Карбапенем ы Монобактам ы Аминоглико зиды n n n Пример бензилпенициллин, ампициллин, оксациллин, амоксициллин, азлоциллин и другие цефазолин, цефалексин, цефамандол, цефотаксим, цефтриаксон, цефоперазон и многие другие меропенем, имипенем азтреонам амикацин, гентамицин, канамицин, сизомицин, тобрамицин и другие

КЛАССИФИКАЦИЯ АНТИБИОТИКОВ по химическому строению n n Характеристика молекулярной структуры Производные диоксиаминофен илпропана n Основные группы антибиотико в Амфенико лы Содержащие n Макролид макроциклическо ы е лактонное Азалиды кольцо n n n Пример Левомицетин (хлорамфеникол) эритромицин, азитромицин, джозамицин, кларитромицин и другие рифаксимин, рифампицин, рифамицин n Ансамицины n n Гликопептиды n n Линкозамиды n клиндамицин, линкомицин n Оксазолидиноны n линезолид n n Разные антибиотики ванкомицин, капреомицин и другие бацитрацин, полимиксин, ристомицин, фузафунжин, фузидиевая кислота, циклосерин и другие

КЛАССИФИКАЦИЯ АНТИБИОТИКОВ ПО МЕХАНИЗМУ ДЕЙСТВИЯ Ингибиторы синтеза клеточной стенки. n Ингибиторы синтеза белка на рибосомах. n Ингибиторы синтеза нуклеиновых кислот n Нарушающие функцию мембран клетки n






Пенициллины n Природные n n Антистафилококковые Бензилпенициллин (пенициллин) Бензилпенициллин прокаин Бензатин бензилпенициллин Феноксиметилпенициллин Бензатин феноксиметилпенициллин Полусинтетические Расширенного спектра Аминопенициллины n Антисинегнойные Карбоксипенициллины n n n Оксациллин n Ампициллин Амоксициллин n Карбенициллин Тикарциллин Уреидопенициллины n n Ингибиторозащищенные n n Комбинированные n Азлоциллин Пиперациллин Амоксициллин/клавуланат Ампициллин/сульбактам Тикарциллин/клавуланат Пиперациллин/тазобактам Ампициллин/оксациллин

Пенициллины Общие свойства: n Бактерицидное действие. n Низкая токсичность. n Выведение в основном через почки. n Широкий диапазон дозировок. n Перекрестная аллергия между всеми пенициллинами и частично цефалоспоринами и карбапенемами. К пролонгированным препаратам пенициллина (депопенициллинам) относятся бензилпенициллин прокаин (новокаиновая соль бензилпенициллина), который имеет среднюю продолжительность действия (около 24 ч), бензатин бензилпенициллин, обладающий длительным действием (до 3 -4 недель), а также их комбинированные препараты. Эти препараты медленно всасываются при внутримышечном введении и не создают высоких концентраций в крови.

Пенициллины Спектр активности n Грам(+) кокки: стрептококки (особенно БГСА), включая пневмококки; энтерококки (устойчивы к низким концентрациям); стафилококки, однако большинство штаммов (S. aureus, S. epidermidis) устойчивы, так как вырабатывают β-лактамазы. n Грам(-) кокки: менингококки; гонококки (в большинстве случаев устойчивы). n Грам(+) палочки: листерии, возбудители дифтерии, сибирской язвы. n Спирохеты: бледная трепонема, лептоспиры, боррелии. n Анаэробы: спорообразующие - клостридии; неспорообразующие - пептококк, пептострептококки, фузобактерии (основной представитель неспорообразующих анаэробов кишечника В. fragilis устойчив); актиномицеты.

АНТИСТАФИЛОКОККОВЫЕ ПЕНИЦИЛЛИНЫ ОКСАЦИЛЛИН n Спектр активности n В отличие от других антибиотиков группы пенициллина устойчив к действию пенициллиназы (из группы β-лактамаз), которую продуцируют 80 -90% штаммов S. aureus. В этом заключается основное клиническое значение препарата. В остальном антибактериальный спектр такой же, как у пенициллина, но степень активности значительно меньше. n Следует учитывать, что в стационарах, особенно в ОРИТ, распространены штаммы S. aureus, устойчивые к оксациллину (метициллину*). Они известны под названием MRSA (methicilline-resistant S. aureus) и характеризуются полирезистентностью. *Метициллин - первый пенициллиназоустойчивый пенициллин. Снят с производства ввиду отсутствия преимущества перед оксациллином, но термин MRSA сохраняется. n

ПЕНИЦИЛЛИНЫ С РАСШИРЕННЫМ СПЕКТРОМ АКТИВНОСТИ Расширенным антимикробным спектром действия обладают аминопенициллины - ампициллин и амоксициллин. АМПИЦИЛЛИН Отличия от пенициллина по спектру активности: n Действует на ряд грамотрицательных бактерий: E. coli, индолотрицательные виды протея (Р. mirabilis), сальмонеллы, шигеллы (последние часто резистентны), Н. influenzae. n Более активен в отношении энтерококков (E. faecalis) и листерий. n Менее активен против стрептококков, пенициллиночувствительных стафилококков, спирохет, анаэробов. n Ампициллин не активен против грамотрицательных возбудителей нозокомиальных инфекций, таких как синегнойная палочка (P. aeruginosa), клебсиеллы, серрации и многие другие. Разрушается стафилококковой пенициллиназой АМОКСИЦИЛЛИН n Флемоксин солютаб, Хиконцил n Производное ампициллина со значительно улучшенной фармакокинетикой приеме внутрь. Во всем мире является ведущим пероральным антибиотиком. По спектру активности близок к ампициллину, но лучше действует на S. pneumoniae и H. pylori. Как и ампициллин, разрушается β-лактамазами.

ЦЕФАЛОСПОРИНЫ 1 поколение Рeros Цефалексин (споридекс, оспексин, лексин) Цефадроксил (дурацеф, цефангин) n Парентерально Цефазолин (кефзол, цефамезин, рефлин) n 2 поколение Рeros Цефуроксим аксетил (зиннат, цефутил) n 3 поколение Рeros Цефиксим (лопракс) Цефтибутен (цедекс) n 4 поколение Рeros Не существует n Парентерально n Парентераль но Цефотаксим натрий но Цефуроксим (клафоран, Цефепим натрий цефантрал) (максипим) (биофуроксим Цефтриаксон Цефпиром , зинацеф, (лендацин, лораксон, йокель, мегион, медаксон, кимацеф) офрамакс, роцефин, терцеф, цефаксон, цефограм) Цефоперазон (цефобид, гепацеф, медоцеф) Цефтазидим (фортум, цефтум, биотум, лоразидим, орзид) n

ЦЕФАЛОСПОРИНЫ Общие свойства n Бактерицидное действие. n Широкий терапевтический диапазон. n Перекрестная аллергия у 5 -10% пациентов с аллергией на пенициллин. n Не действуют на энтерококки, листерии, MRSA. n Разрушаются β-лактамазами расширенного спектра. n Синергизм с аминогликозидами. Нежелательные реакции § Аллергические реакции - крапивница, кореподобная сыпь, лихорадка, эозинофилия, сывороточная болезнь, анафилактический шок. § Гематологические реакции. n Дисульфирамоподобный эффект (цефоперазон, цефамандол, цефотетан) приеме алкоголя. n Повышение активности трансаминаз. n Флебиты (чаще при использовании цефалотина). n Диспептические и диспепсические расстройства.

ЦЕФАЛОСПОРИНЫ Сравнительная антимикробная активность цефалоспоринов Активность в отношении Стабильность к бета-лактамазам Поколения цефалосп Грам+ оринов бактерий Грамбактерий стафилококков грамотрицательных бактерий Первое +++ +/- ++ - Второе ++ +/- Третье + +++ + + Четвертое ++ ++ ++

1 поколени е 2 пок оле ние узкий спектр антимикробной активности Наибольшее клиническое значение имеет их действие на грамположительные кокки, за исключением MRSA и энтерококков. Основное отличие от I поколения - более высокая активности против грамотрицательной флоры. Более активны, чем цефалоспорины I поколения, в отношении грамотрицательных бактерий: Н. influenzae, М. catarrhalis, E. coli, некоторых штаммов клебсиелл, протея (Р. mirabilis, P. vulgaris) и др. По действию на грамположительную флору (стрептококки, стафилококки) близки к 1 поколению Широкий спектр активности Обладают более высокой, чем препараты I-II поколений, активностью против грамотрицательных бактерий из семейства Enterobacteriaceae, включая многие нозокомиальные полирезистентные штаммы. Некоторые из цефалоспоринов III поколения (цефтазидим, цефоперазон) активны против P. aeruginosa. В отношении стафилококков их активность несколько ниже, чем у цефалоспоринов I поколения. Как и все другие цефалоспорины, препараты III поколения не действуют на MRSA и энтерококки, имеют низкую антианаэробную активность, разрушаются βлактамазами расширенного спектра. При тяжелых и смешанных инфекциях парентеральные цефалоспорины III поколения используют в сочетании с аминогликозидами II-III поколений, метронидазолом, ванкомицином. Широкий, хорошо сбалансированный спектр активности Характеризуются большей устойчивостью, чем все другие цефалоспорины, к действию хромосомных и плазмидных β-лактамаз класса Amp. С, которые распространены у нозокомиальных штаммов энтеробактера и цитробактера. По сравнению с цефалоспоринами III поколения более активны против грамположительных кокков (но не действуют на MRSA и энтерококки), грамотрицательных бактерий семейства Enterobacteriaceae и против P. aeruginosa (включая некоторые штаммы, резистентные к цефтазидиму). Активность в отношении грам- бактерий сравнима с активностью фторхинолонов и карбопенемов. 3 пок оле ние 4 пок оле ние

ЦЕФАЛОСПОРИНЫ n n n ЦЕФОПЕРАЗОН/СУЛЬБАКТАМ Сульперазон Представляет собой комбинацию цефоперазона с ингибитором βлактамаз сульбактамом в соотношении 1: 1, является единственным ингибиторозащищенным цефалоспорином. По сравнению с цефоперазоном значительно более активен против микроорганизмов, образующих β-лактамазы - грамотрицательных бактерий семейства Enterobacteriaceae, ацетобактеров. В отличие от других цефалоспоринов хорошо действует на B. fragilis и другие неспорообразующие анаэробы, поэтому при инфекциях брюшной полости и малого таза может применяться в виде монотерапии. По активности в отношении синегнойной палочки соответствует цефоперазону.

МОНОБАКТАМЫ n n n n АЗТРЕОНАМ Азактам Имеет узкий спектр активности, действует бактерицидно на грамотрицательную флору, включая P. aeruginosa, однако аналогично пенициллинам и цефалоспоринам разрушается БЛРС. Кроме того, инактивируется β-лактамазами, которые вырабатываются стафилококками и бактероидами. Несмотря на структурное сходство монобактамов с пенициллинами и цефалоспоринами, перекрестной аллергии с этими группами антибиотиков не отмечается. Нежелательные реакции Гепатотоксичность (желтуха, гепатит). Нейротоксичность. Показания Главное клиническое значение азтреонама заключается в действии на аэробные грамотрицательные бактерии, включая P. aeruginosa; в ряде случаев выступает как альтернатива аминогликозидам. Инфекции НДП (нозокомиальная пневмония), включая муковисцидоз. Инфекции МВП. Интраабдоминальные и тазовые инфекции (в сочетании с антианаэробными препаратами). Инфекции кожи, мягких тканей, костей и суставов. Сепсис.

КАРБАПЕНЕМЫ n n n Карбапенемы имеют структурное сходство с другими β -лактамными антибиотиками, но в отличие от них характеризуются высокой устойчивостью к действию БЛРС (β–лактамазы расширенного спектра) и более широким спектром активности, включая P. aeruginosa и неспорообразующие анаэробы. В группу карбапенемов входят имипенем и меропенем, действующие на многие штаммы грамотрицательных бактерий, устойчивых к цефалоспоринам III-IV поколений. Карбапенемы не активны в отношении MRSA и таких грамотрицательных бактерий, как B. cepacia и S. maltophilia.

АМИНОГЛИКОЗИДЫ I поколение Стрептомицин Неомицин Канамицин II поколение Гентамицин Тобрамицин Нетилмицин III поколение Амикацин Основное клиническое значение аминогликозидов заключается в их активности в отношении грамотрицательных бактерий. Аминогликозиды обладают более быстрым, чем β-лактамы, бактерицидным действием, очень редко вызывают аллергические реакции, но по сравнению с β-лактамами значительно более токсичны. Спектр активности n Грам(+) кокки: стафилококки, включая PRSA и некоторые MRSA (аминогликозиды II-III поколений); стрептококки и энтерококки умеренно чувствительны к стрептомицину и гентамицину. n Грам(-) кокки: гонококки, менингококки - умеренно чувствительны. n Грам(-) палочки: E. coli, протеи (аминогликозиды I-III поколений), клебсиеллы, энтеробактеры, серрации (аминогликозиды II-III поколений); P. aeruginosa (аминогликозиды II-III поколений). n Микобактерии: M. tuberculosis (стрептомицин, канамицин и амикацин). n Анаэробы устойчивы. ! Пневмококки устойчивы к аминогликозидам n Стрептококки, включая группу зеленящих стрептококков, малочувствительны к аминогликозидам. Но применении совместно с пенициллином отмечается выраженный синергизм. Поэтому при лечении, например, бактериального эндокардита, используют сочетание бензилпенициллина (или ампициллина) с гентамицином (или стрептомицином) Нельзя применять для лечения шигеллеза и сальмонеллеза (обусловлено плохим проникновением аминогликозидов внутрь клеток человека, где локализуются шигеллы и

АМИНОГЛИКОЗИДЫ Нежелательные реакции n Ототоксичность (вестибулотоксичность, кохлеатоксичность). n Нефротоксичность. n Нервно-мышечная блокада. Лекарственные взаимодействия n Синергизм при сочетании с пенициллинами или цефалоспоринами (но не при введении в одном шприце!). n Антагонизм с β-лактамными антибиотиками и гепарином при смешивании в одном шприце вследствие физико-химической несовместимости. n Усиление токсических эффектов при сочетании с другими нефротоксичными и ототоксичными препаратами (полимиксин В, амфотерицин В, фуросемид и др. ).

ТЕТРАЦИКЛИНЫ К группе тетрациклинов относятся природный тетрациклин и полусинтетические препараты доксициклин и миноциклин. Общие свойства n Бактериостатическое действие. n Очень широкий спектр активности, но высокий уровень вторичной резистентности многих бактерий. n Перекрестная устойчивость микроорганизмов ко всем препаратам группы. n Высокая частота нежелательных реакций. Нежелательные реакции n Общее катаболическое действие, угнетение белкового обмена, гиперазотемия. n Диспептические явления, эзофагит. n Угнетение нормальной микрофлоры ЖКТ и влагалища; суперинфекции, включая кандидоз ЖКТ и влагалища. n У детей нарушение образования костной и зубной ткани: изменение окраски зубов, дефекты эмали, замедление продольного роста костей. n Фотосенсибилизация (чаще доксициклин). n Гепатотоксичность, вплоть до некроза тканей печени - особенно при патологии печени и быстром внутривенном введении. n Синдром псевдоопухоли мозга: повышение внутричерепного давления при длительном приеме. n Нефротоксичность: развитие тубулярного некроза при использовании просроченных препаратов.

ТЕТРАЦИКЛИНЫ Лекарственные взаимодействия n Антагонизм. Нерастворимые хелатные соединения тетрациклина (но не доксициклина) образуются при реакции с катионами Са, Mg, Al, которые содержатся в пище, особенно в молочных продуктах, и в антацидах. Поэтому пища и антациды значительно снижают биодоступность тетрациклина. n Карбамазепин, фенитоин и барбитураты снижают Т 1/2 доксициклина почти вдвое вследствие ускорения метаболизма препарата в печени. Сходные изменения T 1/2 доксициклина также характерны для лиц, часто употребляющих алкоголь. n Аддитивное действие отмечается при сочетании с некоторыми бактерицидными антибиотиками, например, β-лактамами и/или аминогликозидами). n Синергизм наблюдается при сочетании с макролидами и линкозамидами. ДОКСИЦИКЛИН Вибрамицин, Юнидокс солютаб Лучший на сегодняшний день антибиотик тетрациклиновой группы. Превосходит тетрациклин по активности против пневмококков и лучше переносится.

ТЕТРАЦИКЛИНЫ n ДОКСИЦИКЛИН n Вибрамицин, Юнидокс солютаб n Лучший на сегодняшний день антибиотик тетрациклиновой группы. Превосходит тетрациклин по активности против пневмококков и лучше переносится.

МАКРОЛИДЫ n 14 -членные n 15 -членные (азалиды) n 16 -членные n. Природные n. Эритромицин n. Спирамицин Олеандомицин Джозамицин Мидекамицин n. Полусинтетические n. Рокситромицин n. Азитромицин n. Мидекамицина ацет Кларитромицин Общие свойства n Преимущественно бактериостатическое действие. n Активность против грамположительных кокков (стрептококки, стафилококки) и внутриклеточных возбудителей (микоплазмы, хламидии, легионеллы). n Высокие концентрации в тканях (в 5 -10 -100 раз выше плазменных). n Низкая токсичность. n Отсутствие перекрестной аллергии с β-лактамами.

ЭРИТРОМИЦИН n Первый природный макролид. Один из самых безопасных антибиотиков, с точки зрения развития серьезных нежелательных реакций. РОКСИТРОМИЦИН Рулид, Рокситромицин Лек Полусинтетический 14 -членный макролид. По спектру активности близок к эритромицину. n Отличия от эритромицина: n более стабильная биодоступность (50%), практически не зависящая от пищи; n более высокие концентрации в крови и тканях; n более длительный Т 1/2 - 10 -12 ч; n лучшая переносимость; n менее вероятны лекарственные взаимодействия. КЛАРИТРОМИЦИН n Клацид, Фромилид n n n n n Полусинтетический 14 -членный макролид. По спектру активности близок к эритромицину. Отличия от эритромицина: имеет активный метаболит - 14 -гидрокси-кларитромицин, за счет которого повышена активность против H. influenzae; самый активный из всех макролидов в отношении H. pylori; действует на атипичные микобактерии (M. avium и др. ), вызывающие оппортунистические инфекции при СПИДе; большая кислотоустойчивость и биодоступность (50 -55%), не зависящая от еды; более высокие концентрации в тканях; более длительный Т 1/2 (3 -7 ч); лучшая переносимость; не назначается детям до 6 мес, беременным и кормящим грудью.

Все нижеперечисленные макролиды по сравнению с эритромиицином не зависят от пищи, лучше переносятся, создают более высокие концентрации в тканях, лекарственные взаимодействия не установлены. АЗИТРОМИЦИН n Сумамед Полусинтетический 15 -членный макролид, входящий в подкласс азалидов. n Отличия от эритромицина: n более активен в отношении Н. influenzae, N. gonorrhoeae и H. pylori; n более высокие концентрации в тканях (самые высокие среди макролидов); n имеет значительно более длительный T 1/2 (до 55 ч), что дает возможность назначать препарат 1 раз в день, использовать короткие курсы (1 -3 -5 дней) при сохранении лечебного эффекта в течение 5 -7 дней после отмены; СПИРАМИЦИН n Ровамицин Природный 16 -членный макролид. n Отличия от эритромицина: n активен против некоторых пневмококков и БГСА, резистентных к 14 - и 15 членным макролидам; n действует на токсоплазмы и криптоспоридии; n Как и эритромицин, может применяться у беременных. МИДЕКАМИЦИН, МИДЕКАМИЦИНА АЦЕТАТ n Макропен n n Мидекамицин - природный 16 -членный макролид, мидекамицина ацетат - его полусинтетическое производное, имеющее несколько большую антимикробную активность in vitro и улучшенную фармакокинетику. Отличия от эритромицина: действуют на ряд стафилококков, пневмококков и БГСА, резистентных к 14 - и 15 -членным макролидам; лучше всасываются в ЖКТ (особенно мидекамицина ацетат);

ГЛИКОПЕПТИДЫ В данную группу антибиотиков входят ванкомицин и тейкопланин, обладающие преимущественно бактериостатическим действием и узким спектром активности. Ранее применявшийся препарат ристомицин в настоящее время не используется в связи с высокой токсичностью. n Главное клиническое значение гликопептидов заключается в их активности против MRSA и энтерококков. За рубежом (США, Франция) встречаются ванкомицинорезистентные E. faecium (VRE). В последние годы в ряде стран мира появились S. aureus со сниженной чувствительностью к гликопептидам (VISA, GISA). ВАНКОМИЦИН n Ванкоцин, Эдицин Препарат выбора для лечения стафилококковых инфекций, вызванных MRSA и S. epidermidis, а также энтерококками (E. faecalis, E. faecium), устойчивыми к ампициллину и аминогликозидам n Активен в отношении клостридий, включая С. difficile. Нежелательные реакции n Флебиты (наиболее часто). n При быстром внутривенном введении происходит высвобождение гистамина из тучных клеток с развитием тошноты, гипотензии, гиперемии груди и шеи (синдром «красной шеи» , «красного человека» ). n Ототоксичность: шум в ушах, нарушение слуха (как правило, у лиц пожилого возраста и при нарушении функции почек). n Нефротоксичность: снижение клубочковой фильтрации, интерстициальный нефрит (особенно при сочетании с аминогликозидами и у пациентов с исходными нарушениями функции почек). n Нейтропения. n

ЛИНКОЗАМИДЫ В данную группу входят линкомицин и клиндамицин. Общие свойства n Бактериостатическое действие. n Узкий спектр активности: грамположительные кокки и неспорообразующие анаэробы. n Перекрестная устойчивость микрофлоры к обоим препаратам. n Высокие концентрации в костях и суставах. n Плохое проникновение через ГЭБ. n Отсутствие перекрестной аллергии с β-лактамами. n Относительно частое развитие антибиотико-ассоциированной ( C. difficileассоциированной) диареи. Спектр активности n Грам(+) кокки: стафилококки, включая PRSA; стрептококки, включая пневмококки, но многие пенициллинорезистентные пневмококки устойчивы. Устойчивы MRSA и энтерококки n Анаэробы: пептострептококки, фузобактерии, B. fragilis и др

ЛИНКОЗАМИДЫ ЛИНКОМИЦИН Линкоцин, Нелорен Природный линкозамид, наиболее распространенный в России. n В ЖКТ всасывается плохо: на 30% приеме натощак, а приеме после еды всего на 5%. Метаболизируется в печени, выводится преимущественно через ЖКТ. Т 1/2 - 4 -6 ч. n Линкомицин является альтернативным препаратом при инфекциях, вызванных стафилококками, стрептококками и анаэробами КЛИНДАМИЦИН n Далацин С, Климицин n n n n Является полусинтетическим производным линкомицина. В большинстве стран мира он практически вытеснил линкомицин. Применяется по более широким показаниям. Отличия от линкомицина: значительно более высокая антимикробная активность, однако не действует на линкомицинорезистентные штаммы; в высоких дозах действует на некоторые простейшие (P. falciparum, токсоплазмы); очень высокая биодоступность (90%), не зависящая от пищи; более короткий T 1/2 (2, 5 -3 ч). При тяжёлых инфекциях с подозрением на смешанную флору оба препарата необходимо сочетать с аминогликозидами или фторхинолонами.

ХИНОЛОНЫ / ФТОРХИНОЛОНЫ I поколение нефторированн ые II поколение «грамотрицатель ные» III поколение «респираторны е» IV поколение «респираторные» + «антианаэробные» Налидиксовая кислота Оксолиновая кислота Пипемидовая кислота Ципрофлоксацин Норфлоксацин Офлоксацин Пефлоксацин Ломефлоксацин Спарфлоксацин Левофлоксацин Моксифлоксацин n НАЛИДИКСОВАЯ КИСЛОТА Невиграмон, Неграм Спектр активности n Грам(-) палочки: E. coli, шигеллы, сальмонеллы, протеи, клебсиеллы. Синегнойная палочка, грамположительные кокки и анаэробы устойчивы. Лекарственные взаимодействия n Нельзя сочетать с нитрофуранами, так как резко снижается эффект.

ФТОРХИНОЛОНЫ Преимуществ перед хинолонами I поколения. По фармакодинамике: n более широкий спектр активности, включающий: n n n стафилококки (в том числе PRSA); грамотрицательные кокки (гонококк, менингококк, М. catarrhalis); грамположительные палочки (листерии, коринебактерии, возбудители сибирской язвы); грамотрицательные палочки семейства Enterobacteriaceae, включая полирезистентные (E. coli, сальмонеллы, шигеллы, протеи, энтеробактеры, клебсиеллы, серрации, провиденции, цитробактеры, морганеллы), P. aeruginosa, а также кампилобактеры. отдельные препараты (ципрофлоксацин, ломефлоксацин и др. ) активны против M. tuberculosis; действуют на некоторые внутриклеточные микроорганизмы (легионеллы). По фармакокинетике: n n n создают высокие концентрации в крови и тканях приеме внутрь, причем биодоступность не зависит от времени приёма пищи; хорошо проникают в различные органы и ткани: легкие, почки, простату; имеют длительный Т 1/2, назначаются 1 -2 раза в день. По переносимости: n n нежелательные реакции со стороны ЖКТ и ЦНС встречаются реже; могут быть использованы при почечной недостаточности.

ФТОРХИНОЛОНЫ Микробиологические особенности хинолонов II поколения: n малочувствительны большинство стрептококков (в том числе пневмокок), энтерококки, хламидии, микоплазмы; n не действуют на спирохеты, листерии и большинство анаэробов. Микробиологические особенности хинолонов III поколения: n обладают более высокой активностью в отношении пневмококков (включая пенициллинорезистентные) и атипичных возбудителей (хламидии, микоплазмы). Микробиологические особенности хинолонов IV поколения: n по антипневмококковой активности и действию на атипичных возбудителей превосходят хинолоны предшествующих поколений; n обладают высокой активностью против неспорообразующих анаэробов (B. fragilis и др. ), что дает потенциальную возможность применять их при интраабдоминальных и тазовых инфекциях в виде монотерапии.

ФТОРХИНОЛОНЫ II ПОКОЛЕНИЯ n ЦИПРОФЛОКСАЦИН Ципробай, Ципринол Является «золотым стандартом» среди фторхинолонов. Хорошо всасывается в ЖКТ, биодоступность - 80%. T 1/2 - 4 -6 ч. n НОРФЛОКСАЦИН Нолицин В отличие от других фторхинолонов создает высокие концентрации только в ЖКТ и мочеполовых путях. Биодоступность - 70%. T 1/2 - 3 -4 ч. n ОФЛОКСАЦИН Таривид, Офлоксин Самый активный среди хинолонов II поколения против пневмококков и хламидий. Хуже, чем ципрофлоксацин, действует на P. aeruginosa. Практически полностью всасывается в ЖКТ, биодоступность - 95 -100%. T 1/2 - 5 -7 ч.

ФТОРХИНОЛОНЫ III ПОКОЛЕНИЯ n ЛЕВОФЛОКСАЦИН Таваник n n n Представляет собой левовращающий изомер офлоксацина. Является основным представителем хинолонов III поколения - так называемых «респираторных» хинолонов, отличительным свойством которых является более высокая, чем у хинолонов II поколения, активность против пневмококков (включая пенициллинорезистентные штаммы), микоплазм и хламидий. Имеет высокую биодоступность приёме внутрь - около 100%. Т 1/2 - 6 -8 ч.

ФТОРХИНОЛОНЫ IV ПОКОЛЕНИЯ n МОКСИФЛОКСАЦИН Авелокс n n n Превосходит хинолоны II поколения по активности против пневмококков (включая штаммы, устойчивые к пенициллину и макролидам) и атипичных патогенов (хламидии, микоплазмы). В отличие от всех других фторхинолонов хорошо действует на неспорообразующие анаэробы, в том числе на B. fragilis. Несколько уступает ципрофлоксацину по активности в отношении грамотрицательных бактерий семейства Enterobacteriaceae и синегнойной палочки. Биодоступность приеме внутрь - 90%. Т 1/2 - 12 -13 ч.

ПОЛИМИКСИНЫ Из данной группы бактерицидных антибиотиков, обладающих узким спектром активности против грамотрицательной флоры, в России используются полимиксин В и полимиксин М, за рубежом - колистин (производное природного полимиксина E). n Основное клиническое значение имеет активность полимиксинов в отношении P. aeruginosa. Спектр активности n Грам(-) палочки: Р. aeruginosa, причем устойчивость практически отсутствует; бактерии кишечной группы (Е. coli, сальмонеллы, шигеллы, клебсиеллы и др. ). n Нечувствительны все виды Proteus (отличительный признак), серрации, стрептококки, стафилококки, энтерококки, анаэробы. Фармакокинетика n Не всасываются в ЖКТ и при местном применении. При парентеральном введении плохо проникают через тканевые барьеры, не проходят через ГЭБ, создают низкие концентрации в плевральной и синовиальной жидкостях. Быстро инактивируются в гное. Метаболизируются в печени, выводятся почками. Нежелательные реакции n Выраженная нефротоксичность (необходимо контролировать клубочковую фильтрацию каждые 3 дня). n Нейротоксичность - проявляется поражением центральной и периферической нервной системы. n Нервно-мышечная блокада, причем из всех антибиотиков полимиксин В обладает наибольшей способностью вызывать её. n

ОКСАЗОЛИДИНОНЫ ЛИНЕЗОЛИД Зивокс Первый представитель оксазолидинонов - нового класса синтетических антибактериальных препаратов. Обладает преимущественно бактериостатическим эффектом и узким спектром активности. n Главное клиническое значение линезолида заключается в действии на грамположительные кокки, устойчивые ко многим другим антибиотикам, в том числе на MRSA, пенициллинорезистентные пневмококки и ванкомицинорезистентные энтерококки. n Наличие внутривенной и пероральной лекарственных форм позволяет использовать линезолид для ступенчатой терапии. Спектр активности n Грам(+) кокки: стафилококки - S. aureus (включая MRSA), коагулазонегативные стафилококки; стрептококки, в том числе S. pyogenes и S. pneumoniae (включая пенициллинорезистентные штаммы); энтерококки - E. faecalis, E. faecium (включая ванкомицинорезистентные штаммы). Анаэробы: спорообразующие - клостридии (кроме C. difficile); неспорообразующие - пептострептококки, превотеллы, некоторые штаммы B. fragilis n Грамотрицательная флора устойчива. n Препарат переносится хорошо n

ХЛОРАМФЕНИКОЛ Левомицетин Имеет широкий спектр активности. На пневмококк, менингококк и гемофильную палочку действует бактерицидно, на другую чувствительную микрофлору бактериостатически. n Применяется ограниченно из-за тяжелых нежелательных реакций и вторичной резистентности многих возбудителей. Спектр активности v Грам(+) кокки: стрептококки, включая S. pneumoniae (пенициллинорезистентные пневмококки, как правило, устойчивы); стафилококки (однако многие штаммы устойчивы); энтерококки. v Грам(-) кокки: менингококки, гонококки, М. catarrhalis. v Грам(-) палочки: H. influenzae (включая ампициллинорезистентные штаммы), кишечная палочка, сальмонеллы, шигеллы, бруцеллы, иерсинии. Следует учитывать, что в России 50 -90% шигелл и более 10% сальмонелл устойчивы. v Анаэробы: клостридии, анаэробные кокки, бактероиды (включая полирезистентные B. fragilis). v Риккетсии. n Хорошо всасывается в ЖКТ, биодоступность составляет 70 -80% и не зависит от пищи. Хорошо распределяется в организме: проникает через ГЭБ, ГОБ, создает высокие концентрации в ткани мозга, бронхиальном секрете, желчи. Метаболизируется в печени. Выделяется через почки преимущественно в неактивном состоянии, поэтому при почечной недостаточности дозу можно не снижать. Т 1/2 у взрослых - 1, 5 -3, 5 ч, у детей - 3 -6, 5 ч. Нежелательные реакции n Гематотоксичность: а) обратимая - ретикулоцитопения, тромбоцитопения, анемия, зависящие от суточной и курсовой дозы; б) необратимая - апластическая анемия с почти 100% летальным исходом, которая встречается редко (1 случай на 10 -40 тыс пациентов), может развиваться через 6 -8 недель после отмены препарата, после однократного и даже местного приёма. n «Серый» синдром: у новорожденных вследствие незрелости ферментных систем печени, метаболизирующих хлорамфеникол, препарат кумулируется и оказывает кардиотоксическое действие, что ведет к развитию коллапса, сердечной недостаточности. При этом кожные покровы приобретают серый оттенок. n Гепатотоксичность. n Нейротоксичность: поражение зрительного нерва, периферические полинейропатии. n Диспептические и диспепсические явления. Учитывая высокую частоту и опасность нежелательных реакций, хлорамфеникол рассматривается как резервный антибиотик. n

РИФАМПИЦИН Римактан Полусинтетический бактерицидный антибиотик, обладающий широким спектром активности. Спектр активности n Микобактерии: M. tuberculoisis, M. leprae, "атипичные" микобактерии (M. avium, M. kansasii, M. marinum и др. ). n Грам(+) кокки: стрептококки, включая многие пенициллинорезистентные пневмококки; стафилококки, включая PRSA и многие MRSA. Энтерококки устойчивы. n Грам(-) кокки: гонококки, менингококки. Грам(-) палочки: Н. influenzae (включая штаммы, устойчивые к ампициллину и хлорамфениколу), легионеллы, F. tularensis. n Бактерии кишечной группы (E. coli, сальмонеллы и др. ) малочувствительны. n Анаэробы устойчивы. Нежелательные реакции n гепатотоксичность (вплоть до развития гепатита); n гематотоксичность: тромбоцитопения, гемолитическая анемия; n гриппоподобный синдром (лихорадка, артралгия, миалгия). Чаще развивается при возобновлении приёма препарата после перерыва в лечении. Показания n Основное - туберкулёз, при котором рифампицин применяется обязательно в сочетании с изониазидом и другими противотуберкулёзными препаратами. n Профилактика и лечение атипичных микобактериозов у ВИЧ-инфицированных пациентов (в сочетании с азитромицином, кларитромицином и др. ). n

Лекарственная устойчивость n n Лекарственная устойчивость микроорганизмов — способность микроорганизмов сохранять жизнедеятельность, включая размножение, несмотря на контакт с химиопрепаратами. Различают лекарственную устойчивость, природно присущую микроорганизмам и возникшую в результате мутаций или приобретения чужеродных генов.

Лекарственная устойчивость микроорганизмов нередко носит индуцибельный характер, т. е. экспрессия генов устойчивости происходит лишь после контакта клетки с антимикробным агентом. Примером этого являются частые случаи образования инактивирующего фермента после контакта культуры бактерий с беталактамным антибиотиком. n

Лекарственная устойчивость Лекарственная устойчивость микроорганизмов обусловлена следующими основными механизмами: n ферментативной инактивацией антимикробного агента, n ослаблением его проникновения внутрь клетки возбудителя, n изменением конформации внутриклеточной мишени для антимикробного агента, что препятствует его взаимодействию с мишенью, n образованием повышенного количества молекул мишени, на которую действует данный антимикробный агент.

Лекарственная устойчивость В качестве инактивирующих ферментов известны представители гидролаз: бета-лактамазы, катализирующие расщепление беталактамного кольца у пенициллинов, цефалоспоринов и других бета-лактамов (монобактамов, карбапенемов и т. д. ), эстеразы, воздействующие на эритромицин и некоторые другие антибиотики близкой к нему структуры. v Другая группа инактивирующих ферментов — трансферазы. К ним принадлежат левомицетин- (хлорамфеникол-)-ацетилтрансферазы, аминогликозидацетил, фосфо- или аденилилтрансферазы и фосфотрансферазы, воздействующие на эритромицин v

Определение бета-лактамазной активности n Среда с пенициллином и индикатором фенолрот после инкубирования с чистой культурой бактерий. Желтый цвет –положительный результат, красный - отрицательный

Ингибиторы бета-лактамаз n n n Ингибиторы бета-лактамаз представляют собой бета-лактамные структуры, которые необратимо связываются с ферментами, сами при этом разрушаясь, вследствие чего они получили название суицидных ингибиторов. В настоящее время клиническое значение имеют три таких ингибитора: клавулановая кислота (клавуланат) и два производных пенициллановой кислоты — сульбактам и тазобактам. Они входят в состав комбинированных препаратов, содержащих пенициллиновый антибиотик (ампициллин, амоксициллин, пиперациллин, тикарциллин) и один из ингибиторов β-лактамаз. Такие препараты получили название ингибиторозащищенных пенициллинов (АМОКСИЦИЛЛИН/КЛАВУЛАНАТ (КО-АМОКСИКЛАВ)=Аугментин, Амоксиклав; АМПИЦИЛЛИН/СУЛЬБАКТАМ=Уназин, Сулациллин; ТИКАРЦИЛЛИН/КЛАВУЛАНАТ=Тиментин; ПИПЕРАЦИЛЛИН/ТАЗОБАКТАМ=Тазоцин Применяется также комбинация цефалоспорина III поколения цефоперазона с сульбактамом (сульперазон).

Примеры комбинированных препаратов n АМОКСИЦИЛЛИН (AMOXICILLIN); КЛАВУЛАНОВАЯ КИСЛОТА Сультамициллин: двойной эфир ампициллина (полусинтетического пенициллина) и сульбактама (ингибитора бета-лактамаз). Действует бактерицидно.

Принцип диско-диффузионного метода определения чувствительности к антибиотикам Бактериальную культуру засевают газоном на питательный агар, после чего на его поверхность пинцетом помещают на равномерном расстоянии друг от друга бумажные диски, содержащие определенные дозы разных антибиотиков. Посевы инкубируют при 37 0 С в течение суток. По диаметру зон задержки роста культуры судят о ее чувствительности к соответствующим антибиотикам. При зоне задержки роста до 15 мм культура расценивается как нечувствительная или низко чувствительная, 15 – 24 мм – средняя чувствительность, 25 мм и более – высокочувствительная.
Ход исследования: n n n Приготовить взвесь ЧК м/о Сравнить с 0, 5 по Мак –Фарленду (стандарт мутности взвеси бактерий) Чашку со средой Мюллер- Хинтона засеять ЧК Уложить диски не более 6 Инкубировать в термостате 18 – 24 часа Прочесть и зафиксировать результат

Работа с диспенсером n Быстрее и удобнее использовать диспенсер для дисков

Работа с диспенсером

Чтение результатов


Октодиски

n Измерение зон ингибирования антибиотиками Proto. COL 2 Zone Функциональные возможности: - Определение чувствительности бактерий к антибиотикам (измерение зон ингибиции роста штамма вокруг диска с антибиотиком) - Автоматический учет результатов - Архивирование данных - Выдача результатов на бланке - Автоматическое определение зон ингибиции роста тест - штамма при изучении активности антибиотиков в сырье, фарм. препаратах, а также биологически активных веществ на стадии доклинических испытаний - Автоматический анализ результатов (замер диаметров зон преципитации) при исследовании иммуноглобулинов методом радиальной иммунодиффузии (по Манчини). - Автоматический пересчет числа колоний бактерий с учетом разведения пробы

Определение чувствительности к антибиотикам методом серийных разведений.
Антибиотики. Методы определения чувствительности к антибиотикам..ppt